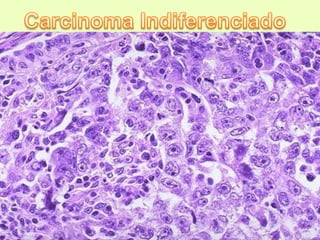

Este documento describe las características de diferentes tipos de tumores malignos. Explica que los tumores se pueden clasificar según su origen epitelial, mesenquimal u otros tejidos. Describe varios carcinomas y adenocarcinomas comunes, así como sarcomas, gliomas y melanomas. Resalta las diferencias histopatológicas que permiten distinguir entre los tipos de tumores.